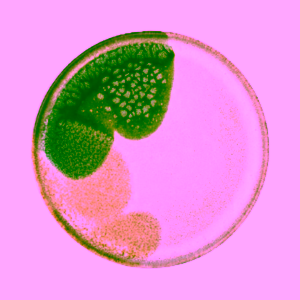
Bloomingville Jules kameninový talíř zelený

Homepage
Trace Minerals
Snadná remineralizace těla
Doplňte důležité minerály v dobře vstřebatelné iontové formě přirozenou cestou. Stačí několik kapek denně pro doplnění více než +75 minerálů a stopových prvků z přírodního zdroje – koncentrované vody z Velkého Solného jezera v USA.
Zlevněné produkty
Natios Výhodný balíček 2 druhů hořčíků Malát a Bisglycinát
Šufan Pistáciová jádra pražená 500 g ZLEVNĚNO
Medarek Balzám na rty Máta 18 g ZLEVNĚNO
Natios Shilajit Extract 500 mg Extra Strength ZLEVNĚNO
Zdravý den Maliny Bio sušené mrazem ZLEVNĚNO
Pelant Chilli sušené hovězí maso 25 g DMT 2.5.2026 ZLEVNĚNO
Sleva
Výběr možností
Tento produkt má více variant. Možnosti lze vybrat na stránce produktu
Organic Labs výhodný set přírodních barviv
Paleo Powders Hovězí kostní dřeň grass-fed ZLEVNĚNO
The Ohm Collection BIO přírodní opalovací krém SPF 15 150ml ZLEVNĚNO

Novinky
Novinka
Výběr možností
Tento produkt má více variant. Možnosti lze vybrat na stránce produktu
Novinka
Výběr možností
Tento produkt má více variant. Možnosti lze vybrat na stránce produktu
Dovážíme do ČR
Více než +200 tisíc spokojených zákazníků ❤️
Klára
Nejlepší majonéza na světě 🙂
Barbora
Nádherná kuchařka a bible zdraví v jednom! ❤️ Je krásná 🙂
Monika
Doufám, že to nezakřiknu, ale za mě 1000% spokojenost. Deodorant krásně voní, a hlavně funguje. Testovala jsem jej i při výstupu na Sněžku, a nemohla jsem tomu uvěřit, že pořád voním. Určitě zkusím i další produkty od této značky.
Kateřina
Tento šampón mi pomohl od svědivé hlavy a lupů během jednoho týdne. Když se smíchá s vodou, tak docela dobře pění, hezky voní a vlasy jsou po umytí jemné. Taky se tolik nemastí a nemusím si je mýt obden, ale stačí 1-2 týdně! Doporučuji.
Michaela
Výborné lanýže, intenzivní oříšková chuť. Bála jsem se, že budou hodně hořké, ale nejsou. Určitě objednám znovu 🙂
Lenka
Už po 3 dnech používání tohoto séra je pleť vypnutá a taková “šťavnatá”. Doporučuji
-eco by sonya serum of plenty
Klára
Boží boží boží! Asi na ní budu i spát 🙂
Lucie
Úžasný máslo, za mě nejlepší z celé nabídky na eshopu! Chutná to jako náplň do Kinder buena akorát bez cukru :)!
Sledujte nás
Rozhovory s inspirativními hosty, nejen z oblasti zdraví, výživy a životního stylu.
Napsali o cukrfree